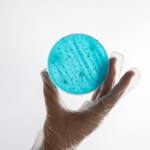

Ofrecemos un amplio rango de tecnología superior que mejora el desempeño de los plásticos en aplicaciones de agricultura, partes automotivas interior y exterior, componentes de construcción y electrónicos, fibras, empaques, paneles fotovoltaicos, piezas en rotomoldeo, entre otros.
– Antioxidantes (Cyanox®)
– Estabilizadores UV de nueva generación (Cyasorb®, Cynergy Solutions®)